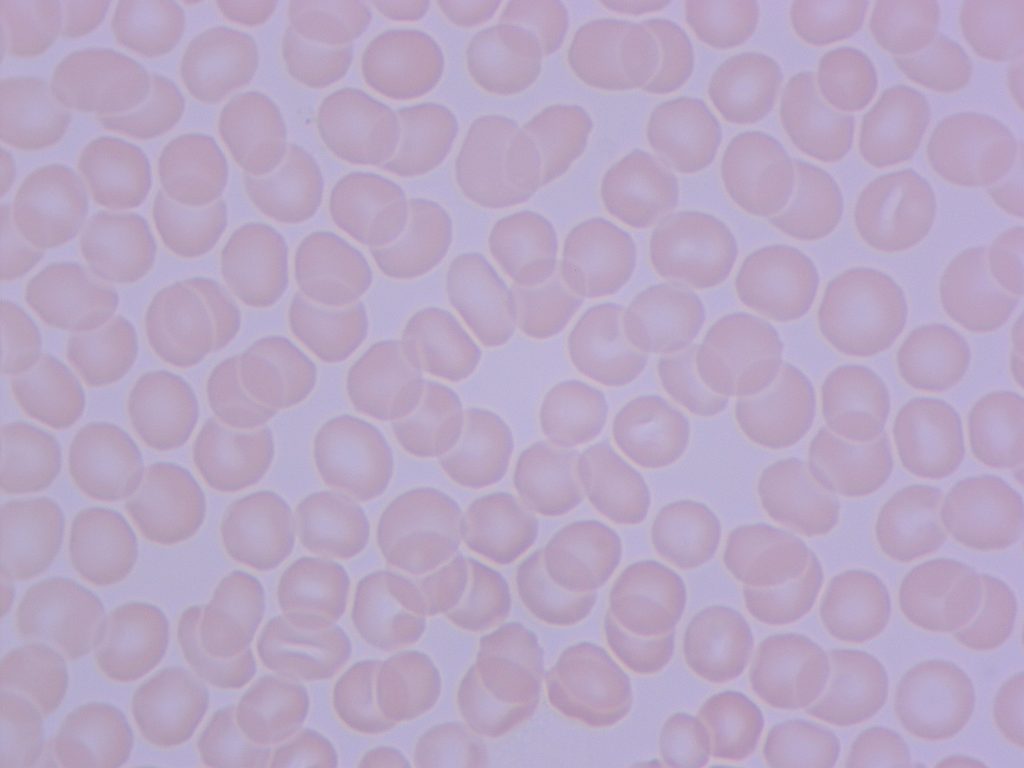
Canlı Su Nedir? 3 Suyu ictikten 20 dakika sonra

Canlı su; kimyasal yapısı değiştirilmeden moleküler yapı formu yeniden düzenlenmiş, oksijen seviyesi maksimuma çıkartılmış, moleküler olarak alan yüklene bilirliği artırılmış ve enerji seviyesi yükseltilmiş, moleküler hafıza yapısı kazandırılmış sudur.
Su, insan hayatı için oksijenden sonra en önemli ikinci ihtiyaçtır. Kanımızı yüzde 80’i kemiklerin yüzde 20’si beyin ve kasların yüzde 70’i sudan oluşuyor. Susuz kalmak ölüme sebebiyet veriyor. Su bütün vücudun metabolizmasını düzenliyor. Organları, beyni, kemikleri ve kasları bunlar bilinen tıbbi gerçekler. Peki su başka neler yapabiliyor. Vücudun ihtiyacı olan saf enerjiyi sudan almamız gerekli hücreler arasındaki iletişimi, beyin aktivitelerini, reflekslerimizi ve hücre yenileme yeteneğini sadece suda bulabiliriz. Yapılandırılmış canlı su aslında tüm organlarımızı ve vücudumuzu yenileyebiliyor.
Enerjisi yüksek ve canlı su bunları çok rahat yapabilir. Maalesef günümüzde tükettiğimiz sular ölü su ve sıfır enerjiye sahiptir. Halk arasında alkali olarak bilinen suyun canlı olması konusu ise doğada olması gereken normal aktivitede ki su yapısıdır. Sanayileşmek de olan dünya, hava kirliliği, doğal kaynakların verimsiz kullanımı suyun yapısını bozmuştur.
Canlı su nasıl olur ?
Öncelikle bilimsel yöntemlerle su (zeroization) yani sıfır noktasına getirerek resetlenir. Suyun doğal yapısına dönmesini sağlanırken, suyun moleküler dizilim formu yeniden yapılandırılır buna bağlı olarak zayıf enerjisini yenilemesi için su hazır hale getirilir. Enerjisini kazanması için proseslerden geçirilen su normal bir suya göre yüzlerce kat daha aktif hale gelir. Bu bir canlıdaki sistemi süratle yapılandırmaya başlar.
Canlı Su ve Oksijen Seviyesi Yükseltilmiş Suyun Hastalardaki Tedavi Süreci Nedir ve Nasıl Olur..?
Laboratuvarda hastalar üzerinde yaptığımız çalışmalarda alınan sonuçları görmektesiniz.
Savunma sistemi zayıflayan kişilerin hastalıklarından dolayı kanda bulunan Eritrositlerin (Alyuvarların) elektrik yüklerini kaybetmesi ve oksijensiz kalmasından kaynaklı simplastlar oluştuğunu ve kan yapısının bozulduğunu görmekteyiz. Kendilerine 1 bardak canlı su verdikten 20 dakika sonra etkileri müthiş
Vücudun temel yapı taşı olan hücreler yaşamlarını ve fonksiyonlarını devam ettirebilmeleri için enerjiye ihtiyaç duyarlar. Hücreler enerji üretimini iki şekilde gerçekleştirebilir.
- Oksidatif fosforilasyon (Oksijenli solunum)
- Non oksidatif fosforilasyon (Oksijensiz solunum)
Nonoksidatif fosforilasyon neticesinde 2 birim enerji (ATP) elde edilirken son ürün olarak ağırlıklı olarak laktik asit elde edilmektedir. Dolayısıyla bu yolla elde edilen enerji miktarı hem az olmakta hem de hücre için zararlı olan laktik asit başta olmak üzere son ürünler ortaya çıkmakta, hücre ortamı asidik olmakta ve en nihayetinde hücreler yapması gererken fonksiyonları yapamadan zarar görmekte ve ölmektedir. Ayrıca hücre ölümü ile ortaya çıkan atıklar da vücuda zarar vermektedirler. Bu aktivitasyon hızlıca bir kısır döngüye girmekte ve insan organizması zarar görmektedir. Elektrik yükünü kaybetmiş ve simblast oluşturmuş olan eritrosit kümeleri doğal olarak kapiller düzeyde çok dar olan damarlardan geçmekte zorlanacak veya geçemeyecek ve bir tıkaç oluşturacaktır. Eritrositler burdan geçemeyince de hedef dokudaki hücreye oksijen ulaştıramayacaktır. Aynı zamanda tıkaç vücutta başka reaksiyonlar sürecini de başlatacaktır.
Oksidatif fosforilasyonda ise 38 birim enerji ( ATP ) elde edilmekte ve reaksiyonlar sonrasında son ürün olarak ağırlıklı olarak su elde edilmektedir. Su ise hem hücreye hem de organizmaya zararsız bir üründür. Substratın (Hammadde) oksidatif fosforilasyona girebilmesi için oksijen molekülü şarttır. Oksijen , vücutta ağırlıklı olarak eritrositler içerisindeki hemoglobin molekülüne bağlıdır, az bir kısmı serbest oksijen şeklinde kan içinde taşınır. Yani; esasen hedef dokudaki hücrenin oksijene ulaşabilmesi için eritrositin hedef dokudaki hücreye ulaşması şarttır.
Canlı ve yüklenebilir enerji seviyesi güçlendirilmiş su ile eritositler tekrar elektrik yükü ile yüklenmekte ve dolayısıyla simblast formu oluşturamamaktadırlar. Böylelikle eritrositler neredeyse tek tek hareket ettiklerinden çok dar kan damarlarından geçebilmekte ve oksijeni hedef hücreye ulaştırabilmektedir. Ayrıca kan içerisinde serbest olarak dolaşan oksijen moleküllerini de arttırdığı için hedef hücrenin oksijenlenmesi artacaktır. Bu da hücrenin fonksiyonlarını normal olarak yerine getirebilmesini sağlayacaktır. Bu hücrelerin öngörülen normal süreçte doğması ve ölmesi demektir.
Bu kısa açıklamadan sonra hangi grup hastalıkların tedavisinde fayda sağlayabileceğine bakalım:
1- Patofizyolojisinde iskemi ( doku oksijenlenmesi azlığı ) olan hastalıklar:
- Kalp damarı hastalıkları : Kalp kirizi , Angina pektoris vb
- Periferik vasküler hastalıklar : Diabetik ayak, emboli, buerger hastalığı,vaskülitler ..vb
- Beyin damar hastalıkları : İskemik inme , vaskülitler .. vb
- Kronik akciğer hastalığı (KOAH) gibi akciğer hastalıkları
2- Kanser hastalıkları: Kanser hücrelerinin oksijenli ortamda üremediği / üremesinin azaldığı bilinen bir gerçektir.
3- Enfeksiyon hastalıkları: Etken i olan mikro organizmanın oksijenli ortamda üreyen mikroorganizmalar hariç ,diğer mikro organizmalar oksijenli ortamda üreyemeyeceklerinden tedaviye yardımcıdır.
Doğaldır ki , bütün hastalıklar ve etki mekanizmasını anlatmak çok mümkün olmadığından detaylı bilgi için ulaşabilirsiniz.
Canlı su vücudun hızla normal aktivitesine dönmesini sağlarken bir çok hastalıklar belirgin bir süre içerisinde düzelmeye başlamaktadır.

Canlı su vücudunuz da bulunan alyuvarları yüzlerce kat enerji ile yükleyerek aktif hale getirir. Vücuttaki hücreleri aktive etmesi vücudun savunmasını arttırarak bozulan kan değerlerini ve organları, süratle onarmasını sağlar. İnsan vücudundaki alyuvarların elektrik yüklerini yani enerjilerini kaybetmesi kanda simplastların oluşmasını sağlar. Kırmızı kan hücresine alyuvar denir. Diğer bir ifade ile alyuvarlar; kana al rengini veren, çekirdeksiz, yuvarlak, küçük hücrelerdir. Alyuvarlar (eritrositler) dolaşım sistemi içinde oksijen ve karbondioksit taşırlar. Alyuvarların enerjisini kaybetmesi oksijeni taşıma kabiliyetini zayıflatır ve vücudun oksijenle beslenmesini engeller. Buda bir çok hastalığın kapısını açar ve vücudun savunması çöker. Kanımızın %50′ si su olduğuna göre hastalık tedavisinde yapılandırılmış (canlandırılmış) suyun şüphesiz ki etkisi çok yüksektir. Ayrıca suyun bir hafızası olduğunu bilmeliyiz. Suyun her bir hafıza hücresinde 440.000 bilgi hücresi bulunmaktadır. Canlı suya ne yapmak istediğini söyleyebilirsiniz peki bu ne anlama geliyor. Ona vücutta hangi davranışı sergilemesi gerektiğini söyleyebilirsiniz.
Canlı su üretimi yapan su arıtma cihazı Royal Green

Sudaki PH değeri nedir
Sulardaki pH yoğunluğu 1’den 14’e kadar rakamlarla ölçülür. PH 7’de su nötrdür. Türk standardına göre içme sularındaki pH değeri 4.5-9.5 arasında olmalıdır. Sudaki pH 7’nin aşağısı ise asidik su, pH 7’nin üzerinde ise bazik sudur. Suyun pH derecesi suyla karışmış hidrojen miktarını gösterir. Topraktaki suyun pH değeri 6 ile 8.5 arasında değişir. Düşük pH’lı su asidik aşındırıcıdır. Ph değeri yüksek olan sular Alkali su olarak adlandırılır.
Alkali Su Nedir
Ph değeri 7 üzerinde olan sulara alkali su denir. Alkali suyun yüzey gerilimi az olan sulardır. Alkali su daha bazik bir yapıya sahip olduğu için vücudumuzdaki toksinlerin nötr hale gelmesini ve daha hızlı atılmasını sağlar. Vücudumuzun pH dengesini sağlayarak hücrelerin yenilenmesini de hızlandırır. PH dengesini sağladığı için vücudun bağışıklık sisteminin daha güçlü olmasına yardımcı olur ve ödem oluşumunu da engeller.
Ölü Su
Fabrikaların, otomobillerin doğayı ve çevreyi kirletmesi suyu öldürdüğü gibi suyun kaynaklardan evlerimize gelene kadar geçtiği kimyasal süreçler suyu tamamen öldürmektedir. Doğal su kaynaklarından alınan suları kaynağından alıp uzaklaştırdığınız anda mevcut teknoloji de kullanılan elektrikli aletlerin çevreye yaydığı kirli elektromagnetik alan suyun moleküler yapısı hızla bozmakta ve suyu öldürmektedir.
Bilim insanları neden bazı kaynak sularının daha şifalı olduğunu, bazılarının ise sadece temiz içilebilir kaynak suları olduğunu araştırırken bazı farklılıkların suya canlılık kattığını fark etmişler. Bu sebepler:
- Suyun temiz olması: Hem hastalık yapıcı mikro-organizmaların, kimyasalların, ağır metallerin vs. olmaması hem de hafızasının temiz olması.
- Suyun oksijen yönünden zengin olması
- Suyun mineral yönünden zengin olması: Vücudumuzda 84 mineral bulunmaktadır.
- Suyun altıgen yapıda olması: Suyun küme yapısının küçük olması.
- Suyun vücut yapısında uygun pH seviyesinde olması
- Suyun antioksidan (ORP değerinin) yüksekliği
- Suyun Aktive Hidrojen içeriğini
Yukarıda saydığım özellikler bir suyun canlılığını belirlemeye yardımcıdır. Bu tip suyu üretebilen Royal Green NSF/ANSI 58 sertifikasına sahip luxplus su arıtma cihazı vardır. Luxplus su arıtma cihazı satın almak için tıklayın.